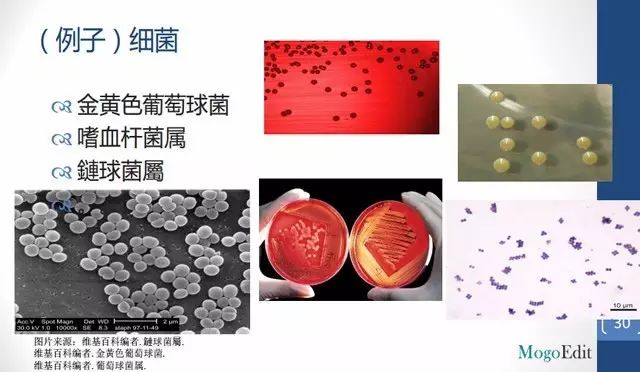
4.jpg

作为一名科研人士,在埋首文献、实验之余,向他人清晰阐述自己的研究内容也同等重要。论文答辩,课堂或实验室报告,参与国内外科研会议,甚至求职,一场高质量的科研报告都会对你有所裨益,而报告之前的准备工作,也是一个帮助你系统分析自身科研进展、串联研究思路的过程。
结合多年参与学术会议、做科研报告的经历,我认为一场成功的科研报告应该具备四个要素:内容品质,专业知识,清晰和有条理,演讲风格。
其中,“内容品质”和“专业知识”属于个人科研领域范畴,其质量的把关和提升主要得益于日常科研经历中的积累与拓展。而如何逻辑清晰地完成一场报告,如何把控自己的演讲风格,PPT该如何制作,则是接下来我要向你们阐述的内容。
内容篇
1.如何编排ppt内容?
科研报告通用架构包括大纲、背景、方法、结果、结论、致谢。在探讨PPT的内容编排之前,我们需要明白制作科研PPT的几项基本原则。
1.1 简洁
第一次做科研报告,想必你有很多话想说——科研的前期准备,实验过程,新的发现,遇到的问题和挫折等等,想把这些内容都展示在PPT里传达给听众。但这样的PPT只是大量杂乱内容的粗暴堆砌,演讲重点无法突出,听众也很难把握你所阐述的核心内容。PPT的“简洁”应该体现在用词,内容,设计等方面。
1.2 实用
PPT的空间很宝贵,因此不要放置多余的内容,尽量保证你所展示的PPT的每一个细节都能为你的报告服务,都是实用的。
有同学可能会问:要不要在PPT中插入动画?我认为,如果动画能帮助你更清楚地表达,让你的报告内容更简单、直接,你就可以适当使用,反之则适可而止,以免背离了PPT制作的“简洁”和“实用”原则。事实上,动画并不会在吸引听众注意方面发挥多少效用。
1.3 连贯性和逻辑性
科研报告中,较强的思维逻辑和语言表达的连贯性也是提升报告整体质量的必要手段。当你使用jargon(专业术语)时,必须给予定义和解释,并注意和上下文之间的连贯表达。有的同学在制作PPT时,会事先考虑它每一页内容的安排和相互之间的衔接,这也是个很好的习惯。总之,一定要把握做报告的逻辑性,应该没有人会相信一个思维混乱、说了上句忘了下句的人能做出严谨的科研报告。
1.4 准确
首先体现在文字表达的准确。记得检查PPT中是否有错别字,这些文字细节都在反映你的严谨度。
其次是内容解释的准确。PPT必须放自己明白的、能够准确解释的东西。如果你安排了连自己都感到生僻的内容,问答环节若是被问到,极容易暴露你知识储备的不足。
最后,参考文献也必须准确。PPT中必须展示参考文献,让大家知道某个内容是从某个研究而来,也令自己的研究内容有据可依。
2.PPT的整体思路该如何架构?
科研报告就像沙漏,除了时间有限,“宽——窄——宽”的沙漏形状也和科研报道的流程是一个道理。
做报告就像讲故事,开篇越宽越好,让听众感到你的讲演主题和他有关联,能够激发他的兴趣,引起共鸣。
其次,随着报告的推进,我们需要将话题收窄到自己的研究方法和研究结果,突出此次报告的主题。
最后,我们需要再一次扩大,让别人清楚的意识到这项研究的重要性。这也就是贯穿科研报告始终的“宽——窄——宽”思路,而“宽”的尺度,则要契合听者的认知程度来定。

下面,依照科研报告的通用架构,我们来看看每个部分应该如何呈现在PPT上。
2.1大纲
大纲部分不需要太多文字,也不需要写完整的句子,写出关键词即可。通用的大纲架构由“背景介绍——方法——结果”三部分组成,切忌不要创新架构,这很容易让听众感到迷惑。
2.2背景资料介绍
这一部分应该阐明前人的研究、这次研究带来哪些新的知识、所应用的理论基础和你的研究目标。
在介绍前人的研究时,你不需要像撰写文献综述一样详细地罗列出每一个相关研究,挑一个与你的报告最直接相关的研究来写即可,注意用词的简单和表达的逻辑性。同时,一定要标注参考文献,因为参考文献是你严谨的学术态度和诚实品质的体现,能够在一定程度上反映你的专业性。
2.3方法
阐述研究方法时,你只需要说明用什么方法达到了什么目的,不需要在PPT上写完整的句子(如果是参与答辩,可以适当多写点儿)。同时,因为科研报告都有问答环节,因此你可以多做几张幻灯片详述研究方法,把它们排在PPT最后,当听者提出了方法方面的疑问,你可以把这一部分PPT展示出来,并结合它进行解答。
做图,是另一种解释研究方法的重要手段。一图胜千字,我建议大家在展示研究方法、结果时尽量用图的形式,因为图片比文字的解释力和吸引力更强,太多的文字会让自己和听者眼花缭乱,图片反而能更清楚的提示要阐述什么内容。
2.4 图表
数据在科研中的重要性想必人尽皆知。在数据较少时,我们最好使用2X2的表格(Table),或者将重点的数据圈出来;数据较多时,我们可以借助图形表达,如曲线图(Line Chart),柱状图(Bar Chart)等等。曲线图用来反应趋势, 柱状图用来反应数据纯粹的量。

图的重点在哪里?使用超过2X2的表格是不是显得有些混乱?

柱状图图例(Bar Chart)
绘制此类图表时,一定色彩的搭配和区分,尽量使用强对比度的颜色,同时要清楚地交待X、Y轴的意义及这张图表意欲传达的重点。显然,相比表格,这幅柱状图在观感和解读上都有一定优势。
不同图表会产生不同的效果,对报告的效率亦会产生直接影响,这对于各个学科都是相通的。
2.5 讨论
根据前面讲到的沙漏理论,讨论部分就是从窄里面出来,把结果引申到一个更宽的话题里面。这里有三个基本原则——首先,页面一定要简洁,可以用图画来帮助解释,不要用太多字,要言简意赅,尽量地简化你的内容,让它看起来不太过混乱。
其次,要注意连贯性跟逻辑性,结论必须基于结果,这就是连贯性,不可以在介绍结果时突然讲到另一个话题。在未来方向的引申也是一样,不要跑太远。
最后就是准确性,放在上面的东西必须是自己能解释的,如果不能解释就不要放上去,否则在问答环节很容易被质疑。
2.6 致谢
在这部分你可以感谢经费提供者、合作者、单位等,不要忘记提供你的联系方式,比如邮箱,万一你的报告引起了陌生人的兴趣,对方可以给你写邮件讨论,或者谈合作也是有可能的。
设计篇
PPT的设计在一定程度上代表了你的形象,也能看出你的专业程度。另外,一个好的PPT设计既可以吸引听众的眼球,也能帮你更清晰地表达。
1.排版
排版最基本的原则是页面信息量不宜太多,每一页最多放3-4个概念,尽量用简单的句子,甚至可以用不完整的词。最好不要在页面中用长句并换行,建议每一句话最好一行字。
2.图片
图片使用同样要适量,图片的清晰度一定要非常高,否则在现场大家很可能会看不清。上面这张图就是一个典型的负面例子,PPT放了很多图,图片贴边严重,没有留白,视觉非常密集。
3.字体
我们挑三个常见的字体来讨论。
最常见的字体是宋体,宋体的笔画比较细,有锯齿,看上去很不清晰,也不舒服。
楷体的问题是,同样的字形字号会小很多,看起来揉在一团,很难分清每一笔的笔画,在投影仪上也很难看清,字号越小越不清楚。
这里推荐使用微软雅黑,它最明显的优势是笔划很均匀,看起来清晰舒服,而且微软雅黑字体在windows里是特别优化过的,边缘很圆滑,PPT里用微软雅黑最清楚,看起来最舒服。
4.配色
颜色方面有两种方案,要么黑字白底,或深字浅底,要么反过来,用白字黑底,或浅字深底。
黑字白底比较适合在较小的教室使用,灯光比较亮,且对准屏幕的时候,视觉效果最好。而浅字适合大的讲台或大教室里。
演讲篇
关于演讲,又有什么技巧应该掌握呢?
1.是否背稿?
相信大家在演讲前都会提前写稿,但我不建议大家把稿子背下来,因为这会让你的演讲十分不生动。万一忘记自己背到了哪里,也会令你更紧张。如果一定要背,我建议大家背下报告的开头5分钟和最后总结的几句话,因为开头是听众们注意力最集中的时候。
至于其他的部分的稿子可以不用写太详细,用列点的方法写下思路,最好写下转折的部分,比如两张PPT 的过度衔接语。
2.时间控制
在家里彩排时,你可以对着镜子去讲,想想哪些部分是自己不太会解释的,这些部分究竟应该删除还是再查一下相关资料?同时想一下自己的逻辑和措辞。
最后,也是最重要的一点,每页PPT的演讲平均是1-2分钟,所以一定控制好演讲时间,保证准时结束。比如,如果你有20分钟的演讲时间,那PPT做15-20张就够了。
3.一些细节
首先是演讲风格,这是一个因人而异的话题,你最好让自己显示得比较积极踊跃,可以微笑,说一些幽默的话。语速尽量慢一点,在演讲期间的停顿是很正常的,一些重要部分你可以稍作停顿。
在演讲的过程中要和在座的人有眼神接触,如果你是那种一看到人就很紧张的类型,也可以把视线放在房间里的中间点,或放在某人的眉毛额头部位。
在演讲时,你可以在房间里走来走去,有研究说这会让演讲看起来比较有趣,但记住千万不要走得太频繁。
4.突发状况
演讲过程中被人打断了怎么办?这里分两种情况。
如果对方问的不是重要的问题。不要烦躁,也不要质问对方,只需要做简单回答,然后继续演讲。如果这个问题后面会提到,你可以说,这是个非常好的问题,我们后面会提。而如果是很复杂的问题,你可以说,谢谢,我们可以把这一问题放在后面的问答环节来解释。
如果对方问的是重要问题怎么办?如果观众大多是专家,你就要尽量深入解释这一问题。而如果不是专家,则可以相对简单一些,把它留在提问时间,因为面对非专家你要花很久的时间来解释,放到最后讨论显然更合适。
还有一种突发情况是,你被人现场质疑。这时你可以尽量去解释,但如果你真的不懂,承认自己不懂,比勉强找一个答案要好,尤其是当对方还是一个专业人士。
为了避免被质疑,你在事前准备时应该尽量只放自己熟悉的东西和确定的资料,不要放不确定的东西。如果实在要放不确定的东西,你可以把它加一个问号在最后,这样可以透过问题让大家不会集中质疑你。
5.问答环节在回答问题时,有五个基本的小技巧。
1、重复问题。现场可能很多人没有听清问题,但重复问题的最重要原因,是能给你时间思考问题,重复的过程其实也是自己在脑袋里思考的过程。
2、表现自信。
3、做好准备。
4、简洁回复。
5、尊重问题及发问的人。
在问答环节中,如果你遇到了无法回答的难题,我最后给大家一些解决方案,可以使用下面的一些技巧。
比如,遇到了无法回答的难题,你可以说——这个问题是很值得研究的下一个课题/这个问题比较复杂,我建议我们结束后有兴趣的可以留下来一起讨论。
而遇到对立的意见,尤其是现场已经快要引起纷争时,你可以说——我们好像都有自己的理据,很难立刻解决,要不我们先去下一题,结束后我们可以再就这个话题讨论。
要记住,科研圈子很小,很多人你在今后还会遇到,要尽量避免引起纷争,尊重对你有质疑的人。
更多关于材料方面、材料腐蚀控制、材料科普等方面的国内外最新动态,我们网站会不断更新。希望大家一直关注中国腐蚀与防护网http://www.ecorr.org
责任编辑:王元
《中国腐蚀与防护网电子期刊》征订启事
投稿联系:编辑部
电话:010-62313558-806
邮箱:fsfhzy666@163.com
中国腐蚀与防护网官方 QQ群:140808414
免责声明:本网站所转载的文字、图片与视频资料版权归原创作者所有,如果涉及侵权,请第一时间联系本网删除。
官方微信
《中国腐蚀与防护网电子期刊》征订启事
- 投稿联系:编辑部
- 电话:010-62313558-806
- 邮箱:fsfhzy666@163.com
- 中国腐蚀与防护网官方QQ群:140808414



